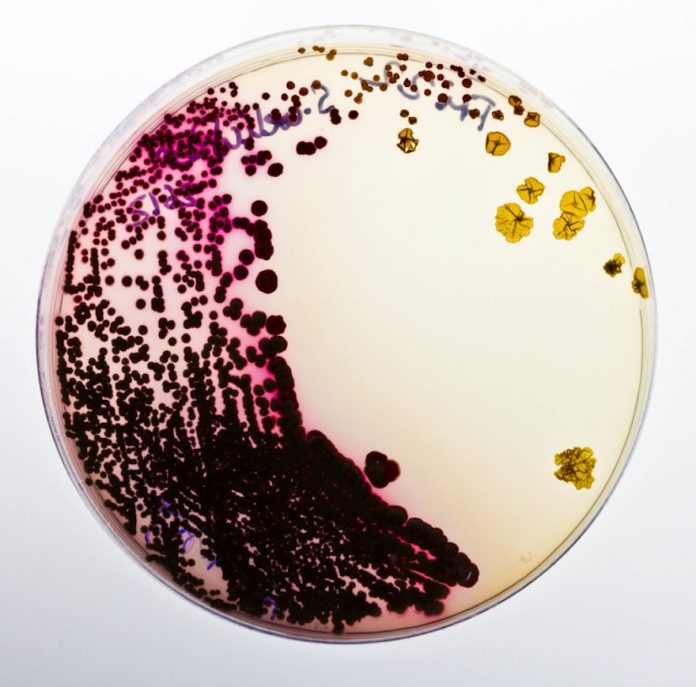

Pantone a longtemps dicté l’horizon de la couleur. Mais derrière la normalisation rassurante des nuanciers, d’autres voix se lèvent. Dans les laboratoires, les ateliers de designers et même dans les champs de culture biologique, une nouvelle génération de pigments voit le jour. Bactéries fluorescentes, encres issues d’algues, teintes générées par l’intelligence artificielle : le rapport du graphisme à la couleur bascule. La palette de demain n’est plus figée, elle est vivante, réactive, éphémère. Une mutation qui interroge à la fois la matérialité de la couleur et son statut de langage technologique
Quand la couleur naît de la matière vivante
À Rotterdam, une équipe de chercheurs cultive des bactéries capables de sécréter des teintes aux reflets changeants. Sous l’effet de la lumière, ces surfaces passent du bleu profond au violet irisé, créant des gammes impossibles à reproduire avec des pigments industriels. Cette approche, baptisée Living Colours, a déjà séduit des studios de design textile, fascinés par l’idée que le visuel puisse être « cultivé » plutôt que fabriqué.
Dans le même esprit, des start-up comme Colorifix au Royaume-Uni utilisent la biologie de synthèse pour teindre des tissus grâce à des micro-organismes. L’objectif est double : réduire l’usage massif de produits chimiques dans l’industrie textile et inventer des couleurs impossibles à obtenir autrement. Le design graphique n’est pas loin : certains de ces textiles ont été exposés comme des affiches vivantes, montrant que la couleur pouvait devenir un support en soi.

Aux États-Unis, la société Living Ink mise sur un autre acteur du vivant : les algues. Transformées en encres, elles donnent naissance à des noirs profonds et mats utilisés pour imprimer des packagings, des affiches ou des étiquettes. Chaque tirage devient une déclaration écologique : montrer qu’une couleur peut être performante sans être polluante.
Les déchets comme ressources chromatiques
L’innovation chromatique ne se limite pas au vivant. La créatrice britannique Alice Potts a choisi de travailler avec les déchets corporels et minéraux. Dans son studio, la sueur cristallisée ou les résidus de minéraux industriels deviennent des cristaux aux teintes translucides, qu’elle fixe sur des textiles ou des objets. Chaque pièce est unique, imprévisible, presque aléatoire. Le design graphique y trouve une nouvelle métaphore : la couleur comme témoin de flux invisibles, comme une empreinte du corps ou de l’industrie sur la matière.

Ce recyclage chromatique s’inscrit dans un mouvement plus large. Dans plusieurs écoles de design européennes, les étudiants travaillent aujourd’hui à partir de déchets de café, de marc de raisin ou de poudres métalliques récupérées. Le pigment se fait récit : il raconte l’histoire de sa provenance, bien plus qu’une teinte abstraite dans un nuancier.
Quand l’algorithme invente la palette
Si la couleur se redéfinit par sa matière, elle se transforme aussi dans le numérique. Plusieurs studios développent aujourd’hui des algorithmes capables de générer des palettes en fonction de données en temps réel : météo, humeur des utilisateurs, rythmes financiers ou variations d’un flux sonore. Les couleurs cessent d’être fixes pour devenir mouvantes, dynamiques, adaptatives.

À Londres, un collectif de designers a ainsi conçu un système d’identité visuelle alimenté par l’intelligence artificielle. Selon l’heure de la journée et l’ensoleillement, le logo de l’institution change de teinte, passant d’un bleu clair matinal à un orange saturé au coucher du soleil. La couleur n’est plus choisie une fois pour toutes, elle devient un organisme numérique en perpétuelle variation.
Cette plasticité soulève cependant une question : que devient la symbolique d’une couleur si elle change sans cesse ? Est-elle encore un repère stable pour l’œil ou une simple traduction de données invisibles ?

Couleur, manifeste écologique et langage technologique
Entre bactéries fluorescentes et algorithmes colorimétriques, deux visions semblent s’opposer mais se rejoignent : la couleur comme matière et la couleur comme information. Dans un cas, elle s’incarne dans le vivant, dans sa fragilité, dans son imprévisibilité. Dans l’autre, elle devient un code, une traduction instantanée de signaux numériques. Dans les deux cas, elle échappe à l’idée de permanence.
Cette mutation résonne fortement avec notre époque. La couleur cesse d’être un simple choix esthétique ou marketing ; elle devient un manifeste écologique lorsqu’elle est produite sans polluer, et un langage technologique lorsqu’elle traduit la dynamique de données. Le graphisme, longtemps attaché à la stabilité des nuanciers, doit apprendre à dialoguer avec des teintes mouvantes, aléatoires, parfois instables.
La couleur de demain n’appartiendra peut-être plus aux imprimeurs ni aux écrans. Elle appartiendra aux vivants et aux machines, à la fois organique et algorithmique. Elle ne sera pas seulement vue, mais ressentie comme une expérience sensible et comprise comme un langage codé.